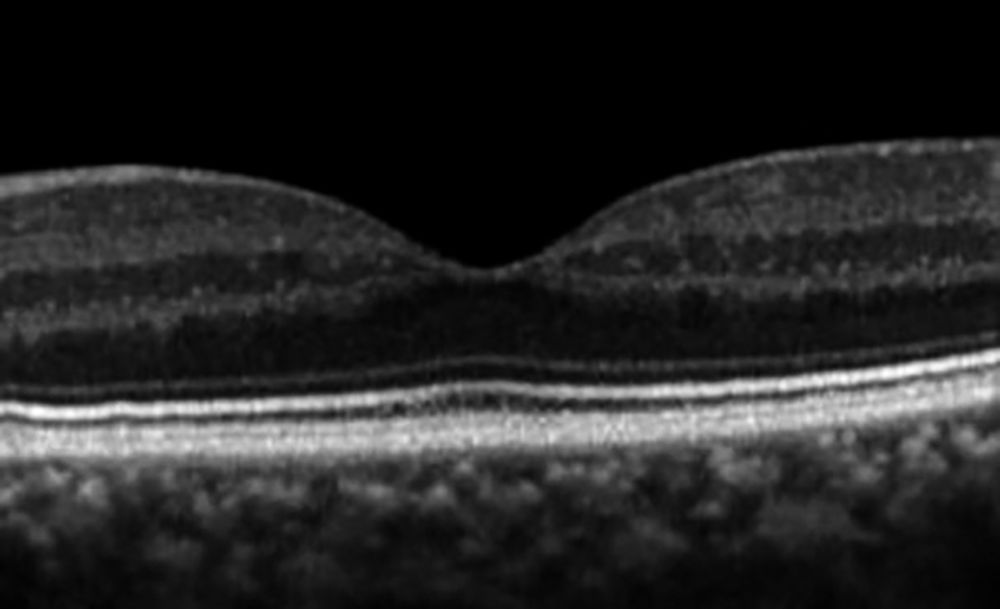

Augenheilkunde heute
Augenheilkunde
In den vergangenen Jahren hat sich die Augenheilkunde in verschiedenen Bereichen erheblich weiterentwickelt. Dies betrifft zum einen technische Neuerungen wie die hochauflösende Bildgebung der Netzhaut mittels optischer Kohärenztomografie (OCT), die uns mittlerweile Bilder in quasi histologischer Auflösung bietet. Dies hat zur Folge, dass wir viele Krankheitsbilder besser pathophysiologisch einordnen können und den Indikationsbereich für therapeutische Strategien anhand von sogenannten Biomarkern neu bewerten. Dabei dienen uns OCT-Biomarker einerseits als prognostische Faktoren, welche Charakteristika beschreiben, die den natürlichen Verlauf einer Erkrankung definieren können. Sie können aber auch als prädiktive Faktoren herangezogen werden, um besser einschätzen zu können, ob eine geplante therapeutische Intervention zum gewünschten günstigen (funktionellen) Ergebnis führen kann. Diese Zusammenhänge möchten wir gerne anhand eines relativ weit verbreiteten Krankheitsbildes aus dem Formenkreis der traktiven Makulaerkrankungen, der sogenannten epimakulären Gliose, darstellen.
Als ein weiteres Krankheitsbild der Netzhaut möchten wir auf den Zentralarterienverschluss (ZAV) eingehen. Dieses liegt im Spannungsfeld zwischen Neurologie und Ophthalmologie. Die Netzhaut stellt einen ausgestülpten Teil des Gehirns da und das Gefäßbett ist bei der Funduskopie direkt einsehbar. Deshalb können Gefäßerkrankungen in der Augenheilkunde direkt beurteilt werden (zum Beispiel diabetische Retinopathie, arterielle Hypertonie, venöse und arterielle Verschlusskrankheiten). Als wichtigste diagnostische Hilfsmittel dienen auch hier die OCT und die Fluoreszenzangiografie. Hierbei wird mittels eines Farbstoffs nicht nur die Durchblutung sichtbar, sondern es kann auch eine vermehrte Durchlässigkeit der Gefäße bei diversen Erkrankungen nachgewiesen werden. OCT-Biomarker weisen hierbei durch ein Ödem, Hyper- und Hyporeflektivität in einzelnen Netzhautschichten auf eine Erkrankungsaktivität hin. In der Situation der Notfallmedizin ist die OCT der Fluoreszenzangiografie weit überlegen, da die Bilder innerhalb kürzester Zeit generiert werden können.
Ein anderer Bereich ist die stete Weiter- bzw. Neuentwicklung von Implantaten zur Behandlung des Glaukoms (Hauptrisikofaktor erhöhter Augeninnendruck). Diese kommen bei Patientinnen und Patienten zur Anwendung, bei denen ein festgelegter Zieldruckbereich zur Verhinderung einer Progression des Glaukomschadens mit der Anwendung verschiedener drucksenkender Augentropfen oder Laserverfahren nicht erreicht werden kann. Ein wichtiges therapeutisches Verfahren ist die filtrierende Operation, bei der das Kammerwasser unter Umgehung der krankheitsbedingt insuffizienten physiologischen Drainagewege direkt aus der Vorderkammer des Auges unter die Bindehaut in ein sich bildendes Sickerkissen abgeleitet wird (zum Beispiel Trabekulektomie = TET). Eine neue und sehr erfolgreiche Modifikation der schon lange praktizierten TET ist die Implantation eines Microshunts (ein schlauchähnliches sickerkissenbildendes Implantat aus einem flexiblen Kunststoff) zur Senkung des Augeninnendrucks. Der Microshunt besteht aus biologisch kompatiblem Material (Verwendung in kardialen Stents), ist abbaubeständig und bietet gegenüber der TET verschiedene Vorteile im Sinne einer geringeren intra-, peri- und postoperativen Komplikationsfrequenz wie postoperative Hypotonie oder Infektionsrisiko des Sickerkissens.
Fall 1: Epiretinale Gliose
Ein 68-jähriger Patient stellt sich in der Sprechstunde vor. Er beschreibt eine Visusminderung am linken Auge. Vorausgegangen war eine unkomplizierte Operation des grauen Stars mit Implantation einer Hinterkammerlinse. Der Patient ist ein wenig enttäuscht, da der subjektiv empfundene Visusanstieg links nicht den Erwartungen und dem Ergebnis am rechten Auge entspricht. Besonders beim Lesen bemerkt er ein Verkippen der Buchstaben, es fällt ihm schwer, die Lesezeile zu halten. Ferner beklagt er ein verzerrtes Bild beim Sehen mit dem linken Auge (Metamorphopsie), welches beim Test mit dem sogenannten Amsler-Gitter (Abbildung 1) reproduzierbar ist. Hierbei blickt der Patient auf einen Fixierpunkt in der Mitte eines karierten Blattes und beobachtet den Verlauf der Linien um denselben. Im Rahmen der Visusprüfung wird die Sehschärfe des linken Auges für die Ferne mit 0.5 gemessen, rechts beträgt sie 1.0. Im Rahmen der direkten Funduskopie mit der 78dpt Lupe zeigt sich im Bereich der Makula ein glitzernder Oberflächenreflex, eine grauweissliche membranöse Struktur mit zugbedingten Netzhautfalten am hinteren Pol. In der durchgeführten OCT-Untersuchung erkennt man auf der Netzhautoberfläche eine hyperreflektive membranöse Struktur, die darunter liegenden Schichten der Netzhaut erscheinen in der horizontalen Ebene verworfen und sind erschwert voneinander abgrenzbar (Disorganization of Retinal Inner Layers: DRIL). Die Traktion überträgt sich bis in die äußeren Netzhautschichten, hier kommt es zu einer traktiven Elevation der Photorezeptoren im Bereich der Fovea („cotton ball sign“).
Diagnose: Epimakuläre (epiretinale) Membran
Idiopathische, primäre epiretinale Gliosen sind besonders bei der älteren Bevölkerung häufig. Die Prävalenz schwankt je nach Literatur zwischen 2 bis 20 Prozent in der Gruppe der 70- bis 80-jährigen Patienten [1]. Die Genese ist nicht vollständig klar, es gibt jedoch einen Zusammenhang mit einer inkompletten Ablösung des Glaskörpers von der Netzhautoberfläche. Sekundäre epiretinale Gliosen entstehen zum Beispiel in Assoziation mit durchgreifenden Defekten der Netzhaut mit der Möglichkeit der Ausschwemmung retinaler Pigmentepithelzellen, nach Laser- oder Kryokoagulation der Netzhaut, Entzündungen (vor allem Uveitis posterior unterschiedlicher Genese) oder verschiedenen vaskulären Erkrankungen [2]. Auch Verletzungen des Bulbus, stumpfes wie auch penetrierendes Trauma, sind ebenfalls wichtige Ursachen für die sekundäre Entstehung epiretinaler Gliosen. Ebenso sind operative Eingriffe wie die Plombenoperation oder Vitrektomie bei Netzhautablösung mit der Bildung sekundärer epiretinaler Membranen assoziiert.

Abbildung 1: Amsler-Gitter – beim einäugigen Blick auf das Gitter können wahrgenommene Verzerrungen auf eine Gliose hinweisen.
Was soll man diesem Patienten raten?
Eine Therapie der epiretinalen Gliose ist im Grunde nur chirurgisch durch Beseitigung der zellulären Proliferationsmembran im Rahmen einer Pars-Plana-Vitrektomie (PPV) möglich. Die PPV ist ein operativer Eingriff, bei welchem der Glaskörper über kleine Zugänge in der Pars Plana des Auges entfernt wird, um Erkrankungen des Glaskörpers oder der Netzhaut, wie beispielsweise eine Netzhautablösung, zu therapieren. Ziel eines solchen Eingriffes ist es, die makuläre Traktion zu beseitigen und ein Rezidiv der Erkrankung zu verhindern. Grundsätzlich betrachtet ist die Bildung einer epimakulären Membran kein ophthalmologischer Notfall, das Sehen ist weder in der Ferne noch in der Nähe akut bedroht. Es gibt keine evidenzbasierten Kriterien für die Indikation eines operativen Eingriffes. Wichtig ist die neue OCT-basierte Einteilung (Abbildung 3) nach Schweregrad von Govetto et al., die heute im klinischen Alltag weit verbreitet ist [3]. Sie teilt die traktiven Veränderungen in vier Schweregrade ein, beginnend mit leichten Veränderungen auf der Netzhautoberfläche bei Grad 1, bis zu einer Affektion der äußeren Netzhaut und einer deutlichen Affektion der Schichten der Netzhaut bei Grad 4 (unser Patient). Neue klinische Studien belegen [4], dass die Operation bei früheren OCT-Stadien zu besseren postoperativen Ergebnissen führt. Dennoch, die Entscheidung sollte mit dem Patienten individuell abgesprochen und das Für und Wider einer Operation unter Berücksichtigung der bestehenden Symptome und Beschwerden sorgfältig abgewogen werden. Wichtig ist zu beachten, dass es im klinischen Alltag nicht immer eine eindeutige Korrelation zwischen dem Aspekt im OCT und der Funktion gibt. In manchen Fällen sind OCT-Veränderungen diskret, die Funktion aber erheblich beeinträchtigt und umgekehrt.

Abbildung 2: Ausgeprägter Befund einer epiretinalen Gliose, die als flächenhafte, weissliche Membran gut erkennbar ist. Ausgeprägte Verziehungen der retinalen Gefäße sind Hinweis auf die starken Traktionen durch die Membran und erklären die funktionellen Beschwerden des Patienten.
Wichtig bei der Beratung der Patienten ist es genau zu eruieren, ob die Patienten durch die Veränderung in ihrem Alltag gestört sind. Dabei ist entscheidend zu erfragen, ob die subjektiven Sehstörungen wie Visusminderung oder Metamorphopsie (aber auch andere wie Mikropsie, Makropsie, Doppelbild) nur monokular beim Blick mit dem betroffenen Auge, sondern auch binokular auftreten. Ist das binokulare Sehen nicht gestört, ist eine Operation nicht dringlich. Photopsien (Lichtblitze), die im Rahmen der Abhebung des Glaskörpers auftreten und Hinweis auf ein Netzhautloch oder eine Netzhautablösung geben können, sind kein typisches Symptom einer epiretinalen Gliose.
Im klinischen Alltag hat sich folgendes Vorgehen bewährt: Unter Berücksichtigung des Verlusts an bestkorrigierter Sehschärfe kann eine Operation ab einem Visus von ≤ 0.5 erwogen werden, unabhängig davon, ob Metamorphopsien bestehen oder nicht. Ein Absinken auf 0.4 würde eine Verschlechterung der Lesefähigkeit bedeuten. Bei besserer präoperativer Sehschärfe empfiehlt sich der Eingriff besonders, wenn der Patient durch Metamorphopsien gestört ist. In manchen Fällen kann auch ein deutlich reduzierter Lesevisus indikationsgebend
sein.
Die Operation – und danach
Entscheidet man sich für einen operativen Eingriff, wird ein PPV durchgeführt. Dabei positioniert man zum Beispiel bei einer 23-Gauge-Vitrektomie 0,7 mm breite Trokare ca. 3,5 mm ausgehend vom Limbus (Übergang von Hornhaut zur Sklera) und kann so in das Auge eingehen, ohne die Netzhaut zu schädigen. Zunächst wird der Glaskörper gründlich entfernt. Entscheidend ist, das die Glaskörperrinde von der Netzhautoberfläche gelöst wird. Anschließend fasst man mit einer feinen Pinzette die Membran und entfernt sie von der Netzhautoberfläche (Abbildung 4). Klinische Studien haben gezeigt, dass die Rezidivrate signifikant reduziert werden kann, wenn neben der Membran zusätzlich die darunterliegende innere Grenzmembran der Netzhaut (Inner Limiting Membrane – ILM) entfernt wird [5, 6]. Diese ist mit 1 µm extrem dünn und mit bloßem Auge trotz hoher Vergrößerung schwer erkennbar. Daher wird sie im Rahmen der Operation mit einem Blaufarbstoff kontrastiert und kann so gepeelt werden, ohne die darunterliegende Nervenfaserschicht zu schädigen. Das Auge kann nach der Operation mit Wasser oder Luft gefüllt werden, letztlich ersetzt das Auge beides im Rahmen der eigenen Flüssigkeitsproduktion in kurzer Zeit. Bei sehr ausgeprägten traktiven Netzhautveränderungen kann zum Ende der Operation ein Steroid intravitreal injiziert werden. Besteht gleichzeitig eine deutliche Linsentrübung, kann die Opertaion des Grauen Stars im Rahmen dieses Eingriffes kombiniert durchgeführt werden.

Abbildung 3: OCT-basierte Einteilung nach Govetto
The Govetto ERM classification system – https://doi.org/10.1016/j.ajo.2016.12.006.
Nach der Operation kommt es in der Regel zu einer funktionellen Verbesserung mit einem Visusanstieg um mehrere Zeilen und eine eventuell vorhandene Metamorphopsie bessert sich oder verschwindet vollständig. Rezidive einer epimakulären Membran sind mit der beschriebenen Operationstechnik sehr selten. Wichtig für die Erwartungshaltung der Patienten ist die Information, dass die Entwicklung der Sehschärfe und anderer subjektiver Symptome nach der Operation Zeit in Anspruch nehmen kann, schnelle positive Ergebnisse wie nach einer Operation des grauen Stares sind eher nicht zu erwarten. Klinische Studien [5, 6] haben gezeigt, dass die Veränderung der Sehschärfe bis zu einem Jahr postoperativ möglich ist. In seltenen Fällen können Symptome wie Doppelbilder, Mikro- oder Makropsie oder auch Metamorphopsie auch neu als Operationsfolge entstehen. Dies unterstreicht noch einmal die Bedeutung der individuellen und gründlichen Aufklärung vor der Operation.

Abbildung 4: Die Abbildung zeigt die einzelnen Operationsschritte des Peelings im Rahmen einer Pars-plana-Vitrektomie. Nach Induktion der hinteren Glaskörperabhebung und Entfernung des Glaskörpers wird Brilliantblau zur besseren Darstellung der Membran appliziert. Nach Ausspülen des Farbstoffs erfolgt unter Sicht mithilfe eines Kontaktglases die vorsichtige Entfernung der Membrana limitans interna sowie der epimakulären Membran mittels einer feinen Pinzette. Abschließend wird ein Flüssigkeits-Luft-Austausch durchgeführt.
Abbildung 5 a: Normales OCT eines gesunden Patienten mit den klar abgrenzbaren retinale Schichten, mittig zeigt sich eine physiologische Verdünnung im Bereich der Fovea centralis.

Abbildung 5 b: OCT-Aufnahme einer epiretinalen Gliose. Man erkennt sehr gut die hyperreflektive Membran auf der Netzhautoberfläche (weißer Pfeil). Durch die Kontraktion der Membran kommt es zu einer Verziehung der Netzhautschichten, die dadurch auch weniger gut voneinander abgrenzbar erscheinen (DRIL). Ist die Traktion sehr stark, werden die Photorezeptoren von dem darunterliegenden retinale Pigmentepithel abgehoben (cotton ball sign). Dies gilt als Hinweis auf eine Verschlechterung der Sehschärfe und korreliert negativ mit dem funktionellen Ergebnis nach der Operation (roter Pfeil).

Abbildung 6: Optische Kohärenztomografie (OCT) des rechten Auges mit beginnendem Sehnervenschaden (Ausdünnung der retinalen Nervenfaserschicht). Diese Diagnostik ermöglicht die quantitative Messung der Nervenfaserschichtdicke am Sehnervenkopf um strukturelle Abweichungen von der Norm, sowie Verlaufsveränderungen frühzeitig zu objektivieren.
Fall 2: Therapeutische Optionen beim primären Offenwinkelglaukom
Ein 88-jähriger Patient mit primärem Offenwinkelglaukom stellte sich mit der Frage nach operativer Versorgung bei einer Augeninnendruckdekompensation in der Sprechstunde vor. Die Erstdiagnose sei wenige Tage zuvor mit Augeninnendruckwerten von 42 mmHg am rechten Auge und 34 mmHg am linken Auge gestellt worden. Beidseits lagen die Werte deutlich über dem Normbereich von 10 bis 21 mmHg. Beidseits bestand aufgrund einer Katarakt eine Visusminderung auf 0,5 rechts und 0,4 links. In der klinisch-ophthalmologischen Untersuchung zeigte sich ein offener Kammerwinkel, funduskopisch die Netzhaut zirkulär anliegend bei einer trockenen, altersbedingten Makuladegeneration und rechts mehr als links beginnender glaukomatöser Papillenexkavation. In der durchgeführten optischen Kohärenztomografie-Aufnahme der Papille konnte der klinische Befund mit einer beginnenden Ausdünnung des retinalen Nervenfaserpolsters ebenso objektiviert werden (siehe roter Pfeil in Abbildung 6, rechtes Auge dargestellt). Anamnestisch bestünden keine weiteren Vorerkrankungen.
Welche therapeutische Option wurde dem Patienten empfohlen?
Nach Beginn der Lokaltherapie mit Dorzolamid und Timolol zweimal täglich zeigte sich eine deutliche Drucksenkung auf 26 mmHg rechts und 20 mmHg links. Es erfolgte daher die Empfehlung zur operativen Versorgung am linken Auge mittels Phakoemulsifikation und Hinterkammerlinsenimplantation (Phako/HKL) und der zusätzlichen Implantation eines Hydrus®-Stent (Nitinol-Implantat in der minimalinvasiven Glaukomchirurgie) im Kammerwinkel (Abbildung 7). Am rechten Auge wurde dem Patienten eine Filtrationschirurgie in Kombination mit Kataraktchirurgie (Phako/HKL und Preserflo® Microshunt-Implantation) empfohlen, mit dem Ziel eine Tropfenfreiheit bei ausreichender Drucksenkung auf das Zielniveau zu erreichen. Da bei fortgeschrittenem Alter des Patienten der Wunsch nach einer möglichst minimalinvasiven Versorgung ohne aufwendige Nachsorge bestand, erfolgte zunächst die Erweiterung der Lokaltherapie rechts um Brimonidin und Latanoprost. Hierunter konnte der intraokulare Druck auf 11 mmHg gesenkt werden, sodass auch rechts die gleiche operative Versorgung wie links möglich war.
Zum Hintergrund
Der therapeutische Ansatz, eine Progression einer glaukomatösen Optikusatrophie zu verhindern, besteht in der Senkung des intraokularen Druckes auf ein Niveau, bei dem keine weitere Schädigung mehr zu erwarten ist. Die Erstlinientherapie besteht in der Durchführung einer selektiven Lasertrabekuloplastik zur Erhöhung des Kammerwasserabflusses oder dem Beginn einer antiglaukomatösen Lokaltherapie. Zur Verbesserung der Therapietreue der Patienten in der Anwendung der Lokaltherapie wurden in den vergangenen Jahren Präparate mit besserer Verträglichkeit für die Augenoberfläche mit konservierungsmittelfreien Formulierungen eingeführt [7]. Des Weiteren bietet die Neuzulassung eines Rho-Kinase-Inhibitors in Kombination mit Prostaglandinanaloga bei hoher Effektivität nun eine weitere Option zur konservativen Drucksenkung. Die häufigste Nebenwirkung liegt hier in der konjunktivalen Hyperämie bei über der Hälfte der Anwender. Hierüber müssen Patienten aufgeklärt werden, um einen Therapieabbruch zu verhindern [8].
Die minimalinvasive Glaukomchirurgie (MIGS, minimal invasive glaucoma surgery) hat außerdem zunehmend an Bedeutung gewonnen. Diese Verfahren zielen darauf ab, den physiologischen Kammerwasserabfluss über das Trabekelmaschenwerk und den Schlemmkanal zu erhöhen und können mit einer Kataraktoperation kombiniert werden. Hierzu zählen neben Stents für den Einsatz in den Kammerwinkeln, zu denen beispielsweise auch der Hydrus®-Stent (Schlemmkanal Microstent) zählt, suprachoroidale Drainageimplantate und trabekuläre Inzisions- bzw. Exzisionstechniken. Der Vorteil dieser Verfahren gegenüber der klassischen Glaukomchirurgie liegt im deutlich reduzierten postoperativen Nachsorgeaufwand bei reduzierter Anzahl schwerwiegender Komplikationen, und deutlich schnellerer Visuserholung. MIGS bieten vor allem bei milden bis moderaten Glaukomstadien eine Therapieoption, da eine Reduktion des Bedarfs an Lokaltherapie über einen längeren Zeitraum zu erwarten ist [9].

Abbildung 7: Hydrus®-Microstent vor Implantation in den Schlemmschen Kanal.
Die Auswahl des entsprechenden Verfahrens sollte aufgrund der anatomischen Gegebenheiten und erforderlichen Reduktion des intraokularen Druckes erfolgen.
Bei Notwendigkeit einer höheren Drucksenkung oder Tropfenfreiheit bei Unverträglichkeit der Lokaltherapie oder zusätzlich bestehenden Begleiterkrankungen, die deren Einsatz limitieren, hat der Preserflo®-Microshunt an klinischer Relevanz und an Bedeutung gewonnen. Im Vergleich zur Trabekulektomie als klassisches filtrierendes Verfahren und Goldstandard der Glaukomchirurgie, ist zwar eine geringere IOD-Senkung zu erwarten, es besteht jedoch eine reduzierte Komplikationsfrequenz (zum Beispiel hypotone Makulopathie) [10 - 14].
Fall 3: Zentralarterienverschluss (ZAV)
In der Notfallsprechstunde stellt sich ein 52-jähriger Patient mit einem plötzlichen, schmerzlosen Sehverlust auf dem gesamten linken Auge vor, der seit zwei Stunden bestehen würde. In der Anamnese gibt der Patient weiter an, dass er den Sehverlust bei beidseits geöffneten Augen bemerkt habe und das Gesichtsfeld nun dunkel sei. Ein plötzlich dunkles Gesichtsfeld ist hochverdächtig auf einen ZAV und bedarf einer sofortigen weiteren Abklärung durch einen Augenarzt [15]. Da der Sehverlust mit beidseits geöffneten Augen registriert wurde und nicht erst nach einer Verdeckung des Partnerauges, kann der Verschlusszeitpunkt exakt bestimmt werden. Bei der Untersuchung zeigt sich am betroffenen Auge lediglich ein Visus von Handbewegung. Bei der Pupillentestung besteht ein relativer afferenter Pupillendefekt (RAPD) auf dem betroffenen Auge. Bei dieser Untersuchung wird die Pupille wechselseitig von inferior beim Blick in die Ferne beleuchtet und so die Lichtsensitivität des einzelnen Auges im Verhältnis zum Partnerauge analysiert. Liegt ein RAPD vor, weitet sich die Pupille auf dem betroffenen Auge und verengt sich bei Beleuchtung des Partnerauges. Ein RAPD objektiviert den angegeben Visus- und Gesichtsfeldverlust. In der Funduskopie zeigen sich fadendünne Netzhautgefäße und eine stehende Blutsäule in den Venen. Eine weißliche Verfärbung der Netzhaut mit einem kirschroten Fleck im Bereich der Makula – das pathognomonische Fundusbild eines ZAV – ist wegen der kurzen Dauer der Ischämie noch nicht sichtbar. In der OCT besteht ein leichtes Ödem der inneren Netzhautschichten, eine Hyperreflektivität der inneren Netzhaut, eine Hyporeflektivität der äußeren Netzhautschichten sowie des retinalen Pigmentepithels, ein Verschwimmen der inneren Netzhautschichten und eine angedeutete prominent Middle Limiting Membrane (pMLM – Abbildung 8 a). Diese OCT-Befunde sind typisch für einen ZAV [16]. Des Weiteren bestehen keine Kau-, Kämm- oder Kopfschmerzen und die Temporalarterien sind nicht druckschmerzhaft und pulsierend tastbar. Es liegt somit klinisch kein Verdacht auf eine Arteriitis temporalis vor.
In einem zweiten Fall stellt sich eine 72-jährige Patientin mit fast identischen klinischen Befunden vor. Der Visus beträgt ebenfalls Handbewegung, es liegt ein RAPD vor und funduskopisch waren die Arterien fadendünn und in den Venen existierte eine stehende Blutsäule. Die OCT zeigte eine etwas geringere Hyper- und Hyporeflektivität, das Ödem der inneren Netzhautschichten war geringer und die pMLM zeigte sich stärker ausgebildet als in Fall 1 (Abbildung 8 b).
Diagnose Zentralarterienverschluss
Die Zentralarterie ist ein Endstromgebiet ohne wesentliche Kollateralen. Bei einem Verschluss der Zentralarterie kommt es deshalb zu einem Infarkt der inneren Netzhaut und somit zu einer Atrophie der betroffenen inneren Netzhautschichten innerhalb von wenigen Monaten. Tiermodelle haben gezeigt, dass die Netzhaut eine ca. vierstündige Ischämietoleranz aufweist [17]. In 95 Prozent der Fälle führt ein ZAV zu einem schweren und dauerhaften Sehverlust [18]. Der ZAV wird hauptsächlich durch arterielle Embolien hervorgerufen. Ein stummer, ischämischer Schlaganfall existiert je nach Studie in 15 bis 37 Prozent [19, 20, 21]. Deshalb sollte wie bei einer Amaurosis Fugax zeitnah eine neurologische sowie kardiovaskuläre Abklärung erfolgen.
Abbildung 8 a, b: Dargestellt ist auf der rechten Seite der horizontale, foveale Schnitt von Fall 1 zwei Stunden nach Symptombeginn. Zur besseren Orientierung ist auf der linken Seite die Lage des OCT-Schnitts auf einer Fundusaufnahme durch einen grünen Pfeil markiert. Auf dem OCT-Schnitt besteht ein leichtes Ödem der inneren Netzhaut, eine Hyperreflektivität der inneren Netzhaut (*), eine Hyporeflektivität der äußeren Netzhautschichten (#) sowie des retinalen Pigmentepithels, ein verschwimmen der inneren Netzhautschichten (&) und eine angedeutete prominent Middle Limiting Membrane (schmaler weißer Pfeil)
Abbildung 8 c, d, e: dargestellt ist auf der rechten Seite der horizontale, foveale Schnitt von Fall 2 – ebenfalls zwei Stunden nach Symptombeginn. Die Lage des Schnitts am Fundus ist in der linken Abbildung wieder markiert durch einen grünen Pfeil. Im Gegensatz zu Fall 1 ist auf dem OCT-Schnitt die Hyperreflektivität der inneren Netzhautschichten noch nicht so stark ausgeprägt. Dafür ist die prominent Middle Limiting Membrane noch deutlicher sichtbar (schmale weiße Pfeile). In den Abbildungen c bis e ist der weitere Verlauf des entsprechenden OCT-Schnitts dargestellt (c = nach zwei Tagen; d = nach einem Monat; e = nach drei Monaten). Hierbei fällt insbesondere eine progrediente Atrophie der inneren Netzhaut über die drei Monate hinweg auf (dicker weißer Pfeil).
Therapiemöglichkeiten
Beim ZAV wurden bereits viele Therapien (unter anderem Bulbusmassage, Parazentese oder eine intraarterielle Fibrinolysetherapie) durchgeführt [22]. Aktuell besteht aber keine evidenzbasierte Therapie für dieses Krankheitsbild. In Analogie zum ischämischen Apoplex konnte in Fallserien als auch Metanalysen eine zeitabhängige Wirksamkeit der intravenösen Fibrinolysetherapie (IFT) gezeigt werden [23]. Folglich wurden prospektiv, randomisierte Multicenter-Studien zur Analyse der IFT angestrebt und durchgeführt [24, 25, 26]. Hierbei erfolgt eine IFT entsprechend den gängigen Standards zur Therapie eines ischämischen Apoplexes.
Sowohl bei Fall 1 als auch Fall 2 erfolgte eine IFT innerhalb von 4,5 Stunden nach Symptombeginn. Bei Fall 1 bestand keine, bei Fall 2 jedoch eine fast vollständige Visuserholung (Fall 1: Visus nach vier Monaten Handbewegungen; Fall 2: nach drei Monaten 0,8). Die Ursache, warum es nur in Einzelfällen zu einer Reperfusion kommt, ist unklar. Der OCT-Verlauf von Fall 2 über drei Monate hinweg ist in den Abbildungen 8 c bis e dargestellt. Trotz der Visuserholung kommt es zu einer dezenten Atrophie der inneren Netzhaut, die auch im Verlust der fovealen Senke sichtbar ist.
Die bereits publizierten Ergebnisse der prospektiv, randomisierten Multicenter-Studien zeigen aber keinen statistisch signifikanten Unterschied zwischen Patienten mit IFT oder einer Therapie mit Acetylsalicylsäure [10, 11]. Die REVISION-Studie wurde nach der Zwischenanalyse Ende Februar 2026 mangels Wirksamkeit abgebrochen. Dementsprechend muss geschlussfolgert werden, dass eine IFT beim ZAV keine Wirksamkeit hat und sollte nicht mehr durchgeführt werden. Dieses Ergebnis hätte wahrscheinlich niemand erwartet, es zeigt aber einmal mehr, von welcher Bedeutung eine evidenzbasierte Medizin ist.
Die Autoren erklären, dass sie keine finanziellen oder persönlichen Beziehungen zu Dritten haben, deren Interessen vom Manuskript positiv oder negativ betroffen sein könnten.
Das Literaturverzeichnis kann im Internet unter www.bayerisches-aerzteblatt.de (Aktuelles Heft) abgerufen werden.
Autorin und Autoren

Professor Dr. Christos Haritoglou
Professor Dr. Maximilan Schultheiß
AugenChirurgie München, Fachärzte für Augenheilkunde Part mbB
Belegärzte in der Augenklinik Herzog Carl Theodor, Nymphenburger Str. 43, 80335 München
Korrespondenz: Christos Haritoglou, christos.haritoglou(at)med.uni-muenchen.de
Teilen:
Das könnte Sie auch interessieren:




